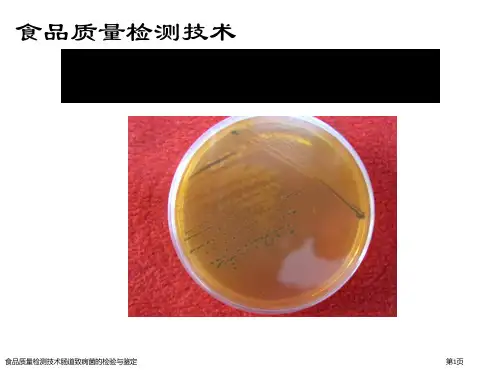

食品志贺氏菌的检验方法
- 格式:docx
- 大小:34.45 KB
- 文档页数:3

食源性致病菌检验标准操作程序福建省疾病预防控制中心二〇一二年十一月一、生物样本检验标准操作程序(一)粪便样本的保存、运送和检测表1 粪便样本的保存、运送和检测培养条件培养基目标病原体温度细菌标本保存和运送1. Cary-Blair 所有食源性致病菌室温增菌液 1. 改良磷酸盐缓冲液小肠结肠炎耶尔森氏菌 4 ℃2. mEC增菌肉汤EHEC O157:H7/STEC 37 ℃3. Preston肉汤弯曲菌微需氧42 ℃4. SBG增菌液沙门氏菌37 ℃5. 3%氯化钠碱性蛋白胨水弧菌37 ℃选择性分离平板1. Mac平板EPEC、STEC、ETEC、EIEC、EAEC、志贺氏菌37 ℃2. XLD平板志贺氏菌37 ℃3. mCCD平板弯曲菌微需氧42 ℃4. 耶尔森氏菌选择性平板小肠结肠炎耶尔森氏菌25 ℃5. 科玛嘉O157:H7显色平板EHEC O157:H7 37 ℃6. 科玛嘉沙门氏菌显色平板沙门氏菌37 ℃7. 科玛嘉弧菌显色平板TCBS平板弧菌37 ℃病毒标本 1. 采便盒轮状病毒、诺如病毒、札如病毒、星状病毒、腺病毒-20 ℃以下(二)检验方法与流程3(三)沙门氏菌和志贺氏菌检测操作程序1 范围本程序规定了粪便标本中沙门氏菌(Salmonella)和志贺氏菌(Shigella)的检验方法。
2 检验程序沙门氏菌和志贺氏菌检验程序见图1。
图1 沙门氏菌和志贺氏菌检验程序3 操作步骤3.1 标本收集标本包括新鲜的或转移至Cary-Blair运送培养基的粪便或肛拭子。
最优标本是转移至Cary-Blair运送培养基的粪便拭子。
肛拭子不是最佳标本,仅在病人无粪便标本时采用。
肛拭子收集后应当目测,需要在拭子上明显见到粪便。
所采集的标本尽快检验,放入Cary-Blair运送培养基中的标本应在冷藏条件下24 h内送检。
新鲜的粪便标本置于清洁、干燥、无肥皂或消毒液残留的容器中,冷藏条件下8 h 内送检。
3.2 分离培养3.2.1 直接分离培养新鲜粪便:无菌拭子采集少量粪便,尽量从可见血或黏液的部位收集;新鲜拭子在XLD 和MAC一区划线;以1 µL无菌接种环或接种针划线分离。

中华人民共和国国家标准食品卫生微生物学检验沙门氏菌、志贺氏菌和致泻大肠中华人民共和国国家标准食品卫生微生物学检验沙门氏菌、志贺氏菌和致泻大肠埃希氏菌的肠杆菌科噬菌体检验方法Mic伪biological examination of food hygi叨ewe Examination of Salmonellae , Shigellae , and diarrhoea causative及cherich血coli妙means of thed泣agnostic typing phage set for enterobacteriaceae前言本标准对GB/T4789.31一1994袭食品卫生微生物学检验沙门氏菌、志贺氏菌和致泻大肠埃希氏菌肠杆菌科噬菌体检验方法》进行修订。
本标准与GB/T4789.31一19料相比主要修改如下:―按照GB/T1.1一2000对标准文本的格式和文字进行修改。
―规范原标准中的“设备和材料”。
本标准自实施之日起,GB/T4789.31一19944同时废止。
本标准由中华人民共和国卫生部提出并归口。
本标准起草单位:江西省卫生防疫站、中国疚病预防控制中心营养与食品安全所。
本标准主要起草人:何晓青、付萍、计融。
本标准于1994年首次发布,本次为第一次修订。
范围本标准规定了应用肠杆菌科噬菌体诊断法检验食品中沙门氏菌、志贺氏菌和致泻大肠埃希氏菌的基本要求、操作程序和结果判定本标准适用于各种食品、食物中毒的检验,也适用于食品从业人员的肠道沙门氏菌和志贺氏菌带菌检验.2、规范性引用文件下列文件中的条款通过本标准的引用而成为本标准的条款。
凡是注日期的引用文件,其随后所有的修改单(不包括勘误的内容)或修订版均不适用于本标准,然而,鼓励根据本标准达成协议的各方研究是否可使用这些文件的最新版本。
凡是不注日期的引用文件,其墩新版本适用于本标准。
GB/T4789.4食品卫生微生物学检验沙门氏菌检验GB/T4789.5一2003食品卫生微生物学检验志贺氏菌检验GB/T4780.6食品卫生微生物学检验致泻大肠埃希氏菌检验GB/T4789.28一2003食品卫生微生物学检验染色法、培养基和试剂3、设备和材料3.1恒温培养箱:36℃士1℃。


食品微生物学检验志贺氏菌检验1、范围适用于食品中志贺氏菌的检验2、设备和材料2.1恒温培养箱:36℃±1℃2.2冰箱:2℃—5℃2.3厌氧培养装置:41.5℃±1℃2.4电子天平;2.5显微镜2.6均质器;2.7无菌吸管;2.8无菌均质杯;2.9无菌培养皿,直径90mm;2.10生化鉴定试剂盒;2.11比浊管及比浊管架;3、培养基和试剂3.1志贺氏菌增菌肉汤-新生霉素3.2麦康凯琼脂(MAC)3.3木糖赖氨酸脱氧胆酸盐琼脂(XLD)3.4志贺氏菌显色培养基3.5三糖铁琼脂3.6营养琼脂平面4、操作步骤4.1增菌以无菌操作取检样25g(mL),加入装有灭菌225mL志贺氏菌增菌肉汤的均质杯,用旋转刀片均质器以8000r/min~10000r/min均质,于41.5℃±1℃厌氧培养16h~20h。
4.2分离取增菌后的志贺氏菌液分别划线接种于XLD琼脂平板和MAC琼脂平板或志贺氏菌显色培养基平板上,于36℃±1℃培养20h~24h,观察各个平板上生长的菌落形态,若出现的菌落不典型或菌落较小不易观察,则继续培养至48h进行观察。
志贺氏菌在不同选择性琼脂平板上的菌落特征见表1.表1 志贺氏菌在不同选择性琼脂平板上的菌落特征4.3 初步生化试验(1)自选择性琼脂平板上分别挑取2个以上典型或可疑菌落,分别接种TSI.半固体和营养琼脂斜面各一管。
置36℃±1℃培养20h~24h,分别观察结果。
(2)凡是三糖铁琼脂中斜面产碱,底层产酸(发酵葡萄糖,不发酵乳糖,蔗糖).不产气(福氏志贺氏菌6型可产生少量气体),不产硫化氢,半固体管中无动力的菌株,挑取其5.3.1中已培养的琼脂斜面上长的菌落,进行生化试验和血清学分型。
5、生化试验(1)生化试验(生化鉴定试剂盒)a.菌悬液的制备取一支盛有2ml无菌水的试管;用接种针挑取可疑菌落至无菌水中;仔细研磨,与标准浊度管比较,制成0.5个麦氏浊度的均匀菌悬液。



志贺氏菌检验志贺氏菌属于肠杆菌科,是一种革兰氏阴性菌,会引起肠道感染,引发肠炎,当人出现连续性腹泻、腹痛等症状的时候,就需要考虑是否感染志贺氏菌。
志贺氏菌的传播途径主要是食物和水,比如沙拉、土豆、金枪鱼、虾、奶制品等,在密闭以及不卫生的条件下志贺氏菌会迅速传播,而且经常出现在人员比较密集的地方,比如餐厅、食堂等地。
食源性志贺氏菌的传播主要是因为从事食品工作的人员感染了志贺氏菌,并且将其传播到食物上所引起的,另外,保存食物的温度不当,也可能引起志贺氏菌。
志贺氏菌检验是临床上检验肠道感染疾病的一个重要途径,在检测过程中常用的方法有以下几种。
一、生化鉴定法常规的生化鉴定方法是志贺氏菌检验过程中的常用方法,需要对细菌进行增殖培养、分离、生化试验、血清学检验等步骤来完成,步骤比较繁琐,而且耗时较长,每一次一般只能检验一个样品,但是检测的结果比较准确,检测稳定性较高,假阳性率低。
二、免疫学检验方法免疫学是检验志贺氏菌最快速、准确的方法,特异性较强,而且灵敏度很高,主要的免疫学检验方法有以下几种:第一,酶联免疫法。
这种方法的灵敏度很高,而且简单快速,检测过程比较稳定,可以进行自动化操作,是志贺氏菌检测过程中最快速的一种方法。
但是,使用酶联免疫法进行检验的时候,影响检测结果的因素较多,而且假阳性率高,所以还需要采用其他的方法进行配合检验。
第二,SPA协同凝集法。
这种方法是使用已知标准血清吸附到含A蛋白的金黄色葡萄球菌表面之后,让金黄色葡萄球菌成为吸附抗体的载体,再根据吸附的结果来诊断是否感染志贺氏菌的一种方法。
三、分子生物学方法分子生物学是建立在很多其他的检测技术基础上的,敏感度高、检测快速,而且特意性高,是生物技术革命的一个重要产物,目前在志贺氏菌的检测过程中十分常见。
志贺氏菌的分子生物学检测方法有以下几种:第一,聚合酶链式反应法,比如常规PCR、多重PCR法、实时荧光PCR法和恒温荧光PCR法等。
以恒温实时荧光PCR法为例,这种方法的原理是利用环介导等温扩增反应为原理进行测量的方法,灵敏度很高,与传统的荧光测量方法相比,灵敏度高出2~5个数量级,而且测量十分迅速,荧光反应的时间较短,一般30-60分钟就可以完成荧光反应。

志贺氏菌检测标准志贺氏菌是一类常见的细菌,它造成了许多消化系统疾病。
为了确保消费者的安全,食品厂商和相关组织都需要进行志贺氏菌的检测。
本文将详细介绍有关志贺氏菌检测的标准,以确保消费者的健康和安全。
第一步骤:选择适当的样本检测开始前,需要选择适当的样本。
这可以是从环境,食品或水源中收集得到的,以确定是否存在志贺氏菌。
通常,人们从肉类,奶类以及其他易受污染的食品等选择样本进行检测。
选择适当的样本对于获得准确的结果非常重要。
第二步骤:采集样本在进行检测前,样本需要采集。
采集需采取规范化程序,以确保采集的样品实际上代表了被检测对象的状况。
采集过程需要避免污染样品,否则可能影响检测结果。
第三步骤:样本处理样品处理是保证测试数据准确性的关键,它可以消除干扰物质和旁边生物。
对于厨房和医疗设施,在处理志贺氏菌样品时应该采取严格的操作。
操作过程应精确规范,以保证样品不与其他样品的任何形式发生交叉污染。
第四步骤:实验室测试在实验室中进行测试是一种保证分析的准确性的方式。
志贺氏菌检测一般使用PCR或者培养方法进行。
不同的实验室可能采用不同的实验操作方法,因此测试数据包括实验的操作条件和环境条件等因素可能会有所不同。
第五步骤:分析测试结果在分析测试结果时,需要考虑到数据的相对稳定性和准确性问题。
分析的结果应包括相关的质量控制数据,以便能够确定测试是否正确进行。
正确的数据分析必须满足比如重复性,标准色谱的基本要求,因此必须引入知识和技术。
总之,通过以上五个步骤,我们可以实现对志贺氏菌的高效检测,并确保消费者的食品安全。
当然,我们在使用志贺氏菌检测标准时,需要时刻关注其技术竞争力和检测过程的规范化,这将为消费者提供一个安全的健康环境,成为维护人民健康的重要保障。